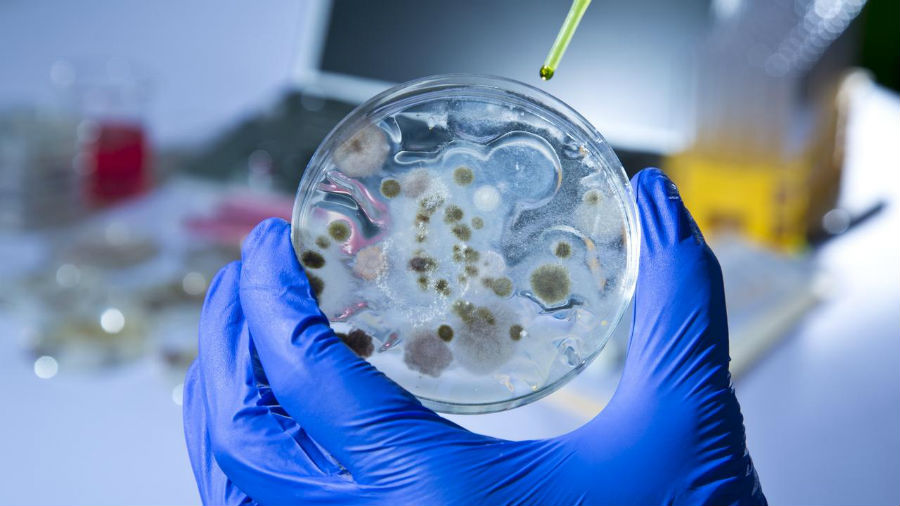
image

Производство слизи в пищеварительном тракте — это естественный процесс, который способствует лучшему прохождению пищи. В норме количество слизи в стуле минимально и незаметно. Однако, если слизь становится видимой, это может указывать на серьезные заболевания.
Слизь вырабатывается клетками слизистой оболочки пищеварительного тракта и состоит из воды, солей и муцина — белков, придающих ей липкость. В толстом кишечнике слизь защищает и увлажняет стенки органа, а в желудке предотвращает повреждение стенок кислотами и ферментами.
Увеличение количества слизи в стуле часто наблюдается при диарее и стойких запорах. Она также может появляться при синдроме раздраженного кишечника и геморрое. Если слизь является единственным симптомом, беспокоиться не стоит, но следует следить за ее количеством.
После нормализации работы кишечника количество слизи обычно уменьшается. Проблемы возникают, если в стуле помимо слизи обнаруживается кровь или появляются другие симптомы.
- Кровь в кале. Наличие крови в стуле — это тревожный сигнал, требующий немедленной консультации с врачом.
- Боли в животе. Повторяющиеся сильные боли, метеоризм и рвота также требуют медицинского осмотра.
- Потеря веса. Чрезмерная потеря веса и изменения в привычках кишечника могут указывать на серьезные проблемы.
- Анемия. Симптомы анемии, такие как бледность кожи и синяки под глазами, требуют внимания.
- Зуд и выделения. У женщин зуд в области половых органов и выделения из влагалища могут свидетельствовать о репродуктивной инфекции.
Слизь в стуле может также указывать на воспалительные заболевания кишечника, такие как болезнь Крона и язвенный колит, а также на бактериальные, вирусные или паразитарные инфекции. В некоторых случаях это может быть признаком непроходимости желудочно-кишечного тракта или заболеваний анальной области, таких как свищи и трещины.
Кроме того, значительное количество слизи может наблюдаться при синдроме раздраженного кишечника и пищевой аллергии.
Инфекционные кишечные инфекции » data-image-caption=»Инфекционные кишечные инфекции » data-medium-file=»https://unclinic.ru/wp-content/uploads/2020/09/infekcionnye-kishechnye-infekcii-656×600.jpg» data-large-file=»https://unclinic.ru/wp-content/uploads/2020/09/infekcionnye-kishechnye-infekcii-656×600.jpg» loading=»lazy» class=»size-medium wp-image-51668″ src=»https://unclinic.ru/wp-content/uploads/2020/09/infekcionnye-kishechnye-infekcii-656×600.jpg» alt=»Инфекционные кишечные инфекции» srcset=»https://unclinic.ru/wp-content/uploads/2020/09/infekcionnye-kishechnye-infekcii-656×600.jpg 656w, https://unclinic.ru/wp-content/uploads/2020/09/infekcionnye-kishechnye-infekcii-768×702.jpg 768w, https://unclinic.ru/wp-content/uploads/2020/09/infekcionnye-kishechnye-infekcii.jpg 900w» sizes=»(max-width: 656px) 100vw, 656px» title=»Слизь в кале — что означает стул со слизью»>
Слизь в стуле у ребенка может быть первым признаком ротавирусной инфекции. Это состояние часто сопровождается повышением температуры, рвотой, жидким стулом с неприятным запахом, сонливостью, раздражительностью и отсутствием аппетита.
Слизь также может указывать на несварение желудка или пищевую аллергию. Обычно она появляется вместе с диареей или полужидким стулом. При аллергии рекомендуется соблюдать элиминационную диету, исключая продукты, вызывающие реакции. Чаще всего это молочные продукты, яйца, крупы и орехи.
У детей слизь в стуле и диарея могут возникнуть после длительной антибактериальной терапии, нарушающей баланс кишечной микрофлоры. Эти недуги чаще всего поражают детей до двух лет. В большинстве случаев симптомы легкие и проходят после прекращения приема лекарства. В тяжелых случаях может развиться псевдомембранозный энтерит, который характеризуется диареей, водянистым стулом с неприятным запахом, а также наличием слизи и крови. Энтерит сопровождается болями в животе, лихорадкой и обезвоживанием.
Обратитесь к врачу, если, помимо слизи, в стуле есть кровь, гной или другие симптомы: боль в животе, метеоризм, рвота, потеря веса, общее недомогание и выделения из влагалища у женщин.
При обращении к врачу с жалобой на слизь в стуле пациенту назначают диагностику, которая включает:
- анализ кала на скрытую кровь;
- анализ крови.
Также проводятся:
- УЗИ брюшной полости;
- эндоскопическое обследование — колоноскопия, ректоскопия или гастроскопия.
Эндоскопические методы позволяют выявить отклонения, а УЗИ менее информативно, но помогает обнаружить патологии печени, желчного пузыря, поджелудочной железы и других органов.
Перед визитом к врачу составьте список продуктов, которые вы ели за последние 48 часов до появления слизи в стуле. Это может помочь в постановке диагноза.
Содержание:
- Почему возникает диарея у собак?
- Формы расстройств желудочно-кишечного тракта.
- Первая помощь собаке при диарее.
- Как предотвратить расстройства ЖКТ?
Если ваша собака несколько раз просилась на улицу, хотя обычно спокойно ждет прогулки, и у нее наблюдается жидкий стул, это может быть признаком проблемы. Обратите внимание на поведение питомца: появились ли рвота, повышенная температура или аллергические высыпания? Давайте рассмотрим причины диареи у собак, способы оказания помощи и методы профилактики расстройств желудочно-кишечного тракта.
Почему возникает диарея у собак?
Это расстройство желудочно-кишечного тракта проявляется учащенным опорожнением кишечника. Несформированный кал выделяется небольшими объемами и обычно возникает из-за воспалительного процесса в тонком кишечнике. Причин диареи у собак много.
На первом месте среди них — неподходящее питание. Желудочно-кишечный тракт собак чувствителен и реагирует на неправильное или несбалансированное питание сбоями, часто проявляющимися в виде поноса или рвоты. Поскольку собака — хищник с соответствующим строением челюсти и ЖКТ, в ее рационе должна преобладать белковая пища с добавлением зерновых и овощей, которые обеспечивают необходимую клетчатку для нормального пищеварения.
Мясо промышленного животноводства, часто используемое в качестве источника белка, не подходит для собак, так как содержит антибиотик окситетрациклин, вызывающий расстройства ЖКТ и пищевые непереносимости. Вместо этого следует использовать мясо фермерского животноводства или рыбу, выловленную в открытом море.
Таким образом, неподходящий корм может вызвать диарею у собаки. Угощение животного лакомствами со стола также недопустимо: жирная, острая, копченая или соленая пища плохо воспринимается организмом питомца и может вызвать серьезные сбои в работе ЖКТ и поджелудочной железы.
Среди других причин диареи у собак можно выделить:
- глистную инвазию (отравление продуктами жизнедеятельности гельминтов);
- инородное тело;
- отравление химическими веществами (бытовая химия, лекарства, консерванты и красители в некачественном корме и т.д.);
- переедание;
- панкреатит;
- дисбактериоз;
- кишечные инфекции;
- энтерит;
- геморрагический лептоспироз;
- новообразования в кишечнике.
Формы расстройств желудочно-кишечного тракта
Расстройством работы желудочно-кишечного тракта считается испражнение более 3-5 раз в сутки. Цвет стула обычно зависит от пищи, но в некоторых случаях он может указывать на проблемы в желудочно-кишечном тракте:
- Черный цвет кала может возникнуть после приема активированного угля или при кровотечении в желудке или двенадцатиперстной кишке. Переваренная кровь придает калу черный цвет.
- Желтый цвет испражнений свидетельствует о желтухе, нарушении работы печени или несварении. Если желтая диарея у собаки сопровождается низкой температурой и сильным неприятным запахом, это может указывать на парвовирусный энтерит.
- Белый понос – признак нарушения работы желчного пузыря или закупорки желчевыводящих путей, так как коричневый цвет кала придает желчь. Отсутствие желчи указывает на проблемы с ее выработкой или доставкой.
- Зеленый цвет может свидетельствовать о дисбактериозе или вирусных и бактериальных заболеваниях. Гниение в желудке и кишечнике возможно, если собака съела испорченную пищу.
Вкрапления крови или слизи в кале чаще всего указывают на поражение желудочно-кишечного тракта паразитами или серьезные вирусные и бактериальные болезни. Необходимо немедленно показать животное ветеринару, если диарея сопровождается следующими симптомами:
- повышение или понижение температуры;
- выраженная слабость;
- рвота;
- отсутствие аппетита и жажды;
- судороги.
Первая помощь собаке при диарее
Уберите корм и предложите собаке только воду. При диарее животное теряет много жидкости, что может привести к обезвоживанию и усилению токсического воздействия. Если понос не сопровождается тревожными симптомами, можно некоторое время наблюдать за собакой. Однако при появлении настораживающих признаков следует обратиться к ветеринару.
Ваша основная задача — обеспечить питомца питьем и изменить рацион. После расстройства желудка собаке потребуется ветеринарная диета, которая поможет бережно восстановить организм. Такой рацион содержит необходимые нутриенты, витамины и микроэлементы, не нагружает ЖКТ и поджелудочную железу, а также не содержит токсинов, вызвавших сбой.
Корм полностью исключается на сутки, после чего его вводят небольшими порциями. Обеспечьте обильное питье, но в малых количествах.
Схему лечения диареи назначает ветеринар. На приеме расскажите, как долго у собаки жидкий стул, была ли рвота и есть ли возможность попробовать несъедобное. Важно также сообщить о времени дегельминтизации и прививок. Лечение зависит от причин нарушения работы ЖКТ. Для выведения токсинов назначают энтеросорбенты, а при глистной инвазии потребуется курс обработки от паразитов. Препарат и схему его приема порекомендует ветеринар.
Лучшая профилактика расстройств ЖКТ – какая она?
Главная мера защиты от диареи у собак — правильный рацион питания. Промышленные корма могут содержать искусственные добавки, антибиотики и другие химические вещества, используемые в животноводстве. Ветеринарные рационы не только лечат диарею, но и предотвращают пищевую непереносимость и кожные болезни.
Основу таких кормов составляют мясо и птица фермерского производства или рыба, выловленная в открытом море. Владельцы собак с непереносимостью куриного или коровьего белка могут выбрать гипоаллергенный корм с белой рыбой, которая является важным источником незаменимых жирных кислот Омега-3 и Омега-6.
Второй компонент лечебного корма — зерновые, выращенные без пестицидов и пригодные для человеческого питания. Их дополняют овощи и фрукты, обеспечивающие корм витаминами и микроэлементами. Уникальные элементы состава — экстракты лекарственных растений, таких как куркума, подорожник, клюква, валериана, алоэ вера и шиповник. Они обладают антисептическими, восстанавливающими и иммуномодулирующими свойствами. Травы в ветеринарных рационах служат естественными добавками, способствующими повышению иммунитета и восстановлению после заболеваний. Низкотемпературная обработка сохраняет все нутриенты.
Такие корма удовлетворяют потребности питомцев, обеспечивают энергией и балансируют работу всех систем организма.
Кроме правильного питания, важно учитывать и другие меры профилактики диареи у собак:
- Ограничьте доступ животного к бытовой химии и медикаментам.
- Следите за собакой на прогулке, предотвращая ее стремление есть испорченные продукты или выброшенные отходы. При необходимости используйте намордник.
- Своевременно обрабатывайте животное от гельминтов и внешних паразитов (блох, власоедов, клещей и т.д.).
- Делайте прививки по возрасту. Многие опасные заболевания можно предотвратить, так как они могут вызвать не только диарею, но и серьезные поражения органов.
- Не гуляйте без прививок. До 3-4 месяцев щенкам лучше избегать улицы, так как многие болезни передаются контактным путем.
Чтобы ваша собака была здорова, позаботьтесь о правильном питании, гигиене и активности.
рекомендуемые статьи
Решение проблем с кожей у собаки
05 июля, 2021
Решение гастрита у кошек
02 июля, 2021
Воспаление уха у собаки, решение отита
30 июня, 2021
Состав препарата СИНУЛОКС
✅ Применение препарата СИНУЛОКС
⏳ Условия хранения СИНУЛОКС
Срок годности СИНУЛОКС
Описание лекарственного препарата СИНУЛОКС
Основано на официальной инструкции по применению препарата СИНУЛОКС для специалистов, утвержденной компанией-производителем для электронного издания справочника Видаль 2011 года.
Дата обновления: 2011.05.18
Организация-разработчик: PFIZER, Inc. (США)
Произведено: HAUPT PHARMA LATINA S.r.l. (Италия)
Активные вещества
- Амоксициллин (amoxicillin) — зарегистрированное ВОЗ международное непатентованное название (Rec.INN).
- Клавулановая кислота (clavulanic acid) — зарегистрированное ВОЗ международное непатентованное название (Rec.INN).
Лекарственная форма
| СИНУЛОКС | Таблетки 50 мг, рег. № ПВИ-2-1.3/01344 от 07.07.09 |
Форма выпуска, состав и упаковка
Таблетки розового цвета с разделительной бороздкой на одной стороне и надписью «Synulox» с другой.
| 1 таб. | |
| амоксициллина тригидрат | 40 мг |
| клавулановая кислота (в форме натриевой соли) | 10 мг |
Вспомогательные вещества: эритрозин (Е127), магния стеарат, натрия гликолат (тип А), безводный коллоидный кремний, сухие дрожжи, микрокристаллическая целлюлоза.
Свидетельство о регистрации № ПВИ-2-1.3/01344 от 07.07.09
Фармакологические (биологические) свойства и эффекты
Антибиотик группы пенициллина. Комбинация амоксициллина и клавулановой кислоты обладает широким спектром антибактериального действия против большинства грамположительных бактерий, включая Staphylococcus spp. (в том числе штаммы, продуцирующие β-лактамазу), Corynebacteria spp., Streptococcus spp., Clostridium spp., Peptostreptococcus spp., а также грамотрицательных бактерий, таких как Escherichia coli (включая штаммы, продуцирующие β-лактамазу), Salmonella spp. (включая штаммы, продуцирующие β-лактамазу), Bordetella bronchiseptica, Proteus spp., Pasteurella spp., Klebsiella spp., Fusobacterium necrophorum и Campylobacter spp.
Синулокс активен против бактерий, продуцирующих β-лактамазу — фермента, разрушающего молекулу антибиотика до его воздействия на бактериальную клетку. Клавулановая кислота, входящая в состав препарата, защищает амоксициллин от действия β-лактамазы, инактивируя ее. Это позволяет амоксициллину быстро оказывать бактерицидный эффект в концентрациях, легко достижимых в организме.
Показания к применению препарата СИНУЛОКС
Для лечения инфекционных заболеваний бактериальной этиологии у собак и кошек применяются:
- кожные заболевания (глубокая и поверхностная пиодермия);
- инфекции мочевыводящих путей;
- респираторные инфекции (включая верхние и нижние дыхательные пути);
- энтериты.
Порядок применения
Препарат назначают внутрь. Синулокс можно давать кошкам и собакам с руки или смешивать с кормом. Прием пищи не влияет на биодоступность препарата.
Дозировка составляет 12.5 мг/кг живой массы дважды в сутки.
| Масса животного (кг) | Количество таблеток на 1 животное 2 раза/сут | ||
|---|---|---|---|
| таблетки 50 мг (шт.) | таблетки 250 мг (шт.) | таблетки 500 мг (шт.) | |
| менее 1 | 0.5 | — | — |
| 1-2 | 0.5 | — | — |
| 3-5 | 1 | — | — |
| 6-9 | 2 | — | — |
| 10-13 | 3 | — | — |
| 14-18 | 4 | — | — |
| 19-25 | — | 1 | 0.5 |
| 26-35 | — | 1.5 | 0.75 |
| 36-50 | — | 2 | 1 |
| более 50 | — | 3 | 1.5 |
Если заболевание трудно поддается лечению, например, при респираторных инфекциях, дозу Синулокса можно увеличить до 25 мг/кг массы животного дважды в сутки.
Продолжительность курса лечения Синулоксом составляет 5-7 суток. При хронических или трудноизлечимых заболеваниях, таких как глубокая пиодермия у собак, курс может длиться 10-28 дней.
Побочные эффекты
При правильном применении препарата побочные эффекты отсутствуют.
В редких случаях возможны аллергические реакции.
Противопоказания к применению препарата СИНУЛОКС
Известная аллергия на пенициллины.
Особые указания и меры личной профилактики
При использовании Синулокса необходимо соблюдать общие правила личной гигиены и техники безопасности, применяемые при работе с лекарственными средствами. После работы с препаратом тщательно вымойте руки теплой водой с мылом. Запрещается принимать пищу и воду во время работы.
Условия хранения СИНУЛОКС
Препарат храните в заводской упаковке, отдельно от пищевых продуктов и кормов, в сухом, защищенном от света, недоступном для детей месте при температуре от 0° до 25°С.
Срок годности СИНУЛОКС
СИНУЛОКС отзывы
Помогите другим с выбором, оставьте отзыв об СИНУЛОКС
Оставить отзыв Если вы хотите разместить ссылку на описание этого препарата — используйте данный код
21.01.2022
Чем симптомы «омикрона» отличаются от симптомов «дельты»?
С ростом случаев заражения можно делать первые выводы о течении инфекции, вызванной новым штаммом.
При омикроне пациенты чаще испытывают слабость, головную боль, заложенность носа, насморк, першение и боль в горле, чихание, снижение аппетита, ломоту в мышцах и суставах. Реже наблюдается потеря обоняния и изменение вкуса. Температура может достигать 38°C и выше, но у многих она остается нормальной или даже пониженной. У детей могут появляться высыпания. Большинство заболевших переносят инфекцию в легкой форме.
Читать на сайте Роспотребнадзора.
Более легкое течение COVID-19 при омикроне может объясняться тем, что вирус размножается в верхних дыхательных путях и редко проникает в легкие. Кроме того, у многих людей уже есть иммунитет к COVID-19, в основном благодаря вакцинации. Изменять схемы лечения коронавируса для заболевших омикроном не требуется; их лечат теми же препаратами и по тем же протоколам. См. «Временные методические рекомендации. Профилактика, диагностика и лечение новой коронавирусной инфекции (COVID-19) Версия 14 (27.12.2021)».
Ваши действия, если вы контактировали с заболевшим
При росте заболеваемости COVID-19 в России риск встречи с носителем вируса высок. Некоторые заболевшие могут не подозревать о своем состоянии, так как не испытывают серьезных симптомов. Однако даже слабые симптомы у носителя не отменяют угрозу для других. Если стало известно, что ваш собеседник или гость заболел, следите за своим состоянием в течение как минимум семи дней. При омикроне симптомы могут появиться быстрее — через 2 дня.
Ваши действия, если вы заболели
- При первых признаках ОРВИ оставайтесь дома, чтобы не заражать других. Изолируйте заболевшего в отдельной комнате и используйте медицинскую маску при общении. Обрабатывайте руки антисептиком.
- Обратитесь за медицинской помощью — позвоните на горячую линию «122» и сообщите о своих симптомах. Укажите наличие температуры, боли в горле, заложенности носа, головной боли, слабости, кашля, затруднения дыхания, болей в груди и высыпаний на коже. Следуйте рекомендациям специалиста.
Особое внимание требуется, если пациент старше 65 лет или имеет хронические заболевания, повышающие риск осложнений COVID-19, такие как диабет, сердечно-сосудистые заболевания, хронические болезни почек и органов дыхания, онкологические заболевания.
Порядок работы поликлиник
Дежурные врачи работают с 8 до 20 часов без выходных. Все пациенты с ОРВИ будут приняты в день обращения. Кроме осмотра и консультации врача, проводятся экспресс и ПЦР тестирования, а при необходимости — дополнительные обследования, такие как анализы крови и ЭКГ.
Для безопасного пребывания в поликлиниках на входе проводится бесконтактная термометрия. Пациенты с повышенной температурой и симптомами ОРВИ направляются по специальной маршрутизации, чтобы избежать смешивания потоков. В помещениях обязательно ношение средств индивидуальной защиты.
Если нужно сделать экспресс-тест
Если вас беспокоит хотя бы один симптом, пройдите экспресс-диагностику, доступную в 71 пункте Москвы. Экспресс-тест на антиген к коронавирусу позволяет за 15 минут с высокой вероятностью выявить COVID-19. Тесты бесплатны для всех желающих.
Для удобства можно заранее заполнить заявку онлайн на сайте и в мобильном приложении ЕМИАС.ИНФО, что сэкономит ваше время. Подробнее об экспресс-тестировании.
Также экспресс-тесты продаются в аптеках для домашнего применения.
Что такое симптоматическое лечение?
Симптоматическое лечение включает лекарства, которые облегчают симптомы, но не воздействуют на причину заболевания. Симптомы омикрона схожи с проявлениями ОРВИ, поэтому в каждой домашней аптечке есть безрецептурные средства для облегчения состояния.
При начале заболевания, как правило, наблюдаются интоксикация, высокая температура, головная и мышечная боль. Рекомендуется пить не менее 2 литров жидкости в сутки, измерять температуру 3 раза в день и принимать жаропонижающие препараты (ибупрофен, ацетилсалициловая кислота). Если температура выше 38°C держится более 3 дней и не снижается, обратитесь к врачу.
Для облегчения першения в горле рекомендуются антимикробные и противовоспалительные средства, полоскания на основе трав или хлоргексидина. Для устранения заложенности носа — сосудосуживающие капли и промывания растворами морской воды. Все эти препараты безрецептурные и часто используются при простудах и ОРВИ.
Учитывая схожесть клинической картины омикрона с ОРВИ, можно использовать противовирусные препараты, такие как интерферон-альфа в виде капель или спреев (гриппферон, генферон лайт и др.). Они помогают снизить вирусную нагрузку на начальных стадиях болезни, облегчить симптомы и сократить длительность заболевания.
Антибиотики не следует применять с первых дней болезни и тем более назначать самостоятельно.
По материалам статьи на сайте ДЗМ.
Что делать, если вы беременны?
Позвоните на горячую линию «122». Сдайте мазок на коронавирус и получите консультацию врача — очную или дистанционную. При температуре выше 38°C вызовите скорую помощь. Беременным с коронавирусом оказывается консультативная помощь и составляется маршрутизация специалистами акушерского консультативно-диагностического центра.
Содержание статьи
Острая кишечная инфекция у детей и взрослых занимает второе место по распространённости после респираторных заболеваний. Эти инфекции поражают желудочно-кишечный тракт и сопровождаются местными и общими симптомами. Особенно тяжело они протекают у младенцев. По данным ВОЗ, ежегодно от кишечных инфекций умирает около 2 миллионов детей младше 5 лет. Поэтому важно своевременно обращаться за медицинской помощью.
Вспышки заболеваний чаще всего происходят в тёплое время года, особенно при повышенной влажности. Болезнетворные микроорганизмы могут выживать вне организма человека до нескольких дней. Это могут быть как вирусы, так и бактерии. Дети раннего возраста наиболее подвержены заражению и тяжелее переносят инфекцию, что увеличивает риск осложнений и серьёзного вреда здоровью. Микроорганизмы попадают в организм через рот, проходят желудок, затем закрепляются в кишечнике и размножаются, что приводит к общей интоксикации.
Разновидности инфекций
Все инфекции делятся на бактериальные и вирусные, каждая из которых имеет свои подвиды.
Бактериальные виды
- Стафилококковая инфекция – проявляется рвотой, диареей и незначительным повышением температуры. Возможны насморк, спазмы в животе и покраснение горла.
- Сальмонеллез – у ребенка наблюдается лихорадка, повышенная температура и жидкий стул нормального цвета.
- Брюшной тиф – проявляется лихорадкой, ломотой в теле, возможны носовые кровотечения, боль в горле и дискомфорт при мочеиспускании.
- Эшерихиоз – симптомы включают рвоту, понос, повышение температуры и колики в животе.
Вирусные формы
- Ротавирус – при кишечном гриппе температура тела достигает 39℃, наблюдаются боли в горле, понос и сильная рвота «фонтаном».
- Энтеровирус – температура может подниматься до 40℃, возможны осложнения, затрагивающие сердце, сосуды, мышцы и нервную систему.
- Аденовирус – у детей проявляется на фоне ринита и конъюнктивита.
Причины развития заболевания
Возбудителями острых кишечных инфекций могут быть патогенные и условно-патогенные бактерии, а также вирусы.
Основные пути передачи вирусов: орально-фекальный и воздушно-капельный. Заражение часто происходит через грязные, несвежие или недостаточно приготовленные продукты, а также через сырую воду. Вирус или бактерия попадают в организм через рот, проходят желудок и закрепляются в кишечнике, где начинают активно размножаться, вызывая интоксикацию.
Основные причины заражения:
- контакт с носителями инфекции;
- некачественные или несвежие продукты;
- загрязненная вода;
- плохо вымытые овощи и фрукты.
Симптомы кишечной инфекции у детей
Признаки заболевания делятся на местные и общие. К общим относятся:
- высокая температура;
- недомогание;
- головная боль;
- обезвоживание.
Местные симптомы:
- поражения желудка и кишечника;
- диарея;
- боли в животе;
- рвота.
При тяжёлой форме острой кишечной инфекции у ребёнка могут развиться осложнения:
- Нейротоксикоз: спутанность сознания, нервозность, судороги.
- Нарушение кровообращения: снижение давления, бледность и синюшность кожи, ухудшение работы сердца.
- Почечная недостаточность: снижение выработки мочи, боли в пояснице.
- Гиповолемический шок от обезвоживания: резкое похудение, пониженная температура, у младенцев — западение родничка.
- Кровотечения в органах ЖКТ.
Наиболее распространённые признаки инфекции — изменения поведения ребёнка. Он становится сонливым, отказывается от еды и проявляет вялость.
Родителей часто интересует, сколько дней длится заболевание. Болезнь не всегда начинается с высокой температуры. Часто сначала возникает рвота и небольшая боль в животе (в первые 12 часов), а температура может даже снижаться. Рвота может повторяться до 30 раз: сначала выходит пища, затем «вода», потом желчь, и в конце — «пустая» рвота. После этого рвота прекращается, ребёнок остаётся вялым и не имеет аппетита. Может начаться лихорадка до 39℃ и водянистая диарея. В течение 2-7 дней диарея стихает, аппетит возвращается, и общее самочувствие улучшается — ребёнок выздоравливает. Весь этот период ребёнок должен находиться под наблюдением специалиста и получать соответствующее лечение.
Болезнь может иметь инкубационный период. Первые симптомы могут появиться через 6-48 часов после заражения.
Способы клинической диагностики
Для точной диагностики и исключения других заболеваний проводятся:
- бактериологические посевы кала и рвоты;
- анализ крови (общий и иммуноферментный);
- копрологический анализ кала.
Важно отличить кишечную инфекцию от заболеваний с похожими симптомами, таких как небактериальное пищевое отравление, воспаление аппендикса или пневмония. При появлении симптомов следует обратиться к детскому инфекционисту или гастроэнтерологу. Врач назначит бактериологические исследования и/или серологические тесты для выявления антител к возбудителям инфекции. При вирусных инфекциях наблюдается общее ухудшение состояния и высокая температура, тогда как бактериальные инфекции проявляются четкими локальными симптомами.
Лечение острой кишечной инфекции у детей
Первое желание родителей — помочь ребенку, начать лечение до консультации с врачом.
Важно! Если ребенок жалуется на затуманенное или ухудшившееся зрение, или есть признаки косоглазия, немедленно вызывайте «Скорую». Это может быть признаком ботулизма, который опасен для жизни.
До прихода врача необходимо оказать первую помощь:
- Уложите ребенка в постель и поставьте рядом емкость для рвоты.
- При ознобе накройте ребенка одеялом и положите грелку к ногам.
- Давайте теплое питье, предварительно промыв желудок, дав 1-1,5 литра воды и вызвав рвоту.
- Если у ребенка сильная рвота и понос, дайте «Регидрон», чтобы предотвратить обезвоживание.
- При сильной боли в животе можно дать «Но-Шпу», но обезболивающие перед приходом врача могут затруднить диагностику.
Если следовать рекомендациям врача, бороться с обезвоживанием и соблюдать диету, ребенок сможет выздороветь за 4-5 дней.
Рекомендации при острой форме заболевания
Профилактика обезвоживания
Многие инфекции проходят самостоятельно благодаря иммунной системе ребенка. Главная задача — поддержать организм в этот период. Наиболее опасным последствием является обезвоживание из-за рвоты и диареи. Важно восполнять уровень жидкости. Для этого можно использовать «Регидрон», «Орасан», «Хумана электролит», «Гастролит» и другие препараты. Также можно приготовить раствор самостоятельно: на 1 л воды добавьте 2 ст. л. сахара, 1 ч. л. соды и 1 ч. л. соли. Перед употреблением раствор следует нагреть до температуры тела ребенка для лучшего всасывания.
Меры против высокой температуры
Повышенную температуру необходимо сбивать. Жар способствует дополнительной потере жидкости, что усиливает обезвоживание. Чтобы избежать этого и общей интоксикации, следует дать жаропонижающее средство, например, «Ибуклин», «Нурофен детский» или «Ибупрофен».
Антибиотики
ВОЗ рекомендует применять противомикробные препараты при кишечных инфекциях в следующих случаях:
- диарея продолжается несколько дней;
- наличие крови в рвоте или стуле;
- тяжелая форма холеры.
Сорбенты
Сорбенты можно давать ребенку при кишечной инфекции для предотвращения интоксикации. Хотя ВОЗ не имеет прямых доказательств их эффективности против заболевания, они не наносят вреда, поэтому педиатры часто их назначают.
Диета при кишечной инфекции у детей
Состояние ребенка может ухудшиться при употреблении молочных и мясных продуктов. В идеале рекомендуется голодание на 1-2 дня. Однако не все родители согласны с этим, и такие меры не подходят детям с низкой массой тела. ВОЗ предлагает продолжать кормить ребенка как обычно, но лучше перейти на вегетарианскую диету с преобладанием жидкой пищи. Полезны овощи и крупы.
Профилактика кишечных инфекций
Чтобы снизить риск заражения кишечной инфекцией, специалисты медицинского центра «СМ-Клиника» рекомендуют:
- соблюдать личную гигиену;
- употреблять только чистые и свежие продукты;
- подвергать продукты необходимой термической обработке;
- пить кипячёную воду;
- избегать контактов с больными.
Педиатры «СМ-Клиника» не советуют самостоятельно лечить ребёнка от острой кишечной инфекции. При ухудшении состояния малыша обратитесь к врачу.
Источники:
- А.Н. Сурков. Тактика лечения острых кишечных инфекций у детей // Вопросы современной педиатрии, 2011, т.10, №6, с.141-147.
- Д.В. Усенко, А.А. Плоскирева, А.В. Горелов. Острые кишечные инфекции у детей в практике педиатра: возможности диагностики и терапии // Вопросы современной педиатрии, 2014, т.13, №3, с.12-20.
- Х.С. Хаертынов, В.А. Анохин. Современные принципы терапии острых кишечных инфекций // Казанский медицинский журнал, 2010, т.1, №XCI.
Информация в статье носит справочный характер и не заменяет консультацию квалифицированного специалиста. Не занимайтесь самолечением! При первых признаках заболевания обратитесь к врачу.
Цены
| Наименование услуги | Цена |
|---|
Все врачи детские гастроэнтерологи
-
Хватова Елена Анатольевна
Врач второй квалификационной категории
Основная специальность: гастроэнтеролог
Дополнительная специальность: педиатр
Стаж: 22 года
Приём:- Дунайский пр-т, д. 47 (м. Дунайская)
- ул. Малая Балканская, д. 23 (м. Купчино)
Цена приёма: 1950 рублей
-
Ежевская Елена Николаевна
Основная специальность: гастроэнтеролог
Стаж: 24 года
Приём:- Дунайский пр-т, д. 47 (м. Дунайская)
Цена приёма: 1950 рублей
- Дунайский пр-т, д. 47 (м. Дунайская)
-
Денисова Анна Алексеевна
Кандидат медицинских наук
Основная специальность: гастроэнтеролог
Стаж: 16 лет
Приём:- Дунайский пр-т, д. 47 (м. Дунайская)
Цена приёма: 1950 рублей
- Дунайский пр-т, д. 47 (м. Дунайская)
-
Вострикова Екатерина Борисовна
Основная специальность: гастроэнтеролог
Стаж: 14 лет
Приём:- пр-т Ударников, д. 19 корп. 1 (м. Ладожская)
Цена приёма: 1950 рублей
- пр-т Ударников, д. 19 корп. 1 (м. Ладожская)
-
Грек Елена Анатольевна
Врач высшей квалификационной категории
Основная специальность: гастроэнтеролог
Дополнительные специальности: педиатр, иммунолог
Стаж: 24 года
Приём:- ул. Малая Балканская, д. 23 (м. Купчино)
Цена приёма: 3900 рублей
- ул. Малая Балканская, д. 23 (м. Купчино)
-
Терехова Ольга Борисовна
Основная специальность: гастроэнтеролог
Дополнительная специальность: педиатр
Стаж: 14 лет
Приём:- пр-т Ударников, д. 19 корп. 1 (м. Ладожская)
Цена приёма: 1950 рублей
- пр-т Ударников, д. 19 корп. 1 (м. Ладожская)
-
Михайлова Виктория Евгеньевна
Основная специальность: гастроэнтеролог
Дополнительная специальность: педиатр
Стаж: 10 лет
Приём:- Выборгское шоссе, д. 17 корп. 1 (м. Пр-т Просвещения)
Цена приёма: 1950 рублей
- Выборгское шоссе, д. 17 корп. 1 (м. Пр-т Просвещения)
-
Белотицкая Валерия Эдуардовна
Основная специальность: гастроэнтеролог
Дополнительная специальность: педиатр
Стаж: 6 лет
Приём:- Дунайский пр-т, д. 47 (м. Дунайская)
Цена приёма: 1950 рублей
- Дунайский пр-т, д. 47 (м. Дунайская)
-
Дедкова Ольга Владимировна
Врач первой квалификационной категории
Основная специальность: гастроэнтеролог
Стаж: 7 лет
Приём:- ул. Маршала Захарова, д. 20 (м. Ленинский проспект)
Цена приёма: 1950 рублей
- ул. Маршала Захарова, д. 20 (м. Ленинский проспект)
-
Ермакова Антонина Александровна
Основная специальность: гастроэнтеролог
Дополнительная специальность: гепатолог
Стаж: 26 лет
Приём:- ул. Малая Балканская, д. 23 (м. Купчино)
Цена приёма: 1950 рублей
- ул. Малая Балканская, д. 23 (м. Купчино)
-
Манило Елена Владимировна
Основная специальность: гастроэнтеролог
Дополнительная специальность: гепатолог
Стаж: 6 лет
Приём:- Дунайский пр-т, д. 47 (м. Дунайская)
Цена приёма: 1950 рублей
- Дунайский пр-т, д. 47 (м. Дунайская)
-
Бочкова Ольга Юрьевна
Врач первой квалификационной категории
Основная специальность: гастроэнтеролог
Дополнительная специальность: педиатр
Стаж: 14 лет
Приём:- Выборгское шоссе, д. 17 корп. 1 (м. Пр-т Просвещения)
Цена приёма: 1950 рублей
- Выборгское шоссе, д. 17 корп. 1 (м. Пр-т Просвещения)
-
Хватова Елена Анатольевна
Врач второй квалификационной категории
Основная специальность: гастроэнтеролог
Дополнительная специальность: педиатр
Стаж: 22 года
Приём:- Дунайский пр-т, д. 47 (м. Дунайская)
- ул. Малая Балканская, д. 23 (м. Купчино)
Цена приёма: 1950 рублей
-
Грек Елена Анатольевна
Врач высшей квалификационной категории
Основная специальность: гастроэнтеролог
Дополнительные специальности: педиатр, иммунолог
Стаж: 24 года
Приём:- ул. Малая Балканская, д. 23 (м. Купчино)
Цена приёма: 3900 рублей
- ул. Малая Балканская, д. 23 (м. Купчино)
-
Ермакова Антонина Александровна
Основная специальность: гастроэнтеролог
Дополнительная специальность: гепатолог
Стаж: 26 лет
Приём:- ул. Малая Балканская, д. 23 (м. Купчино)
Цена приёма: 1950 рублей
- ул. Малая Балканская, д. 23 (м. Купчино)